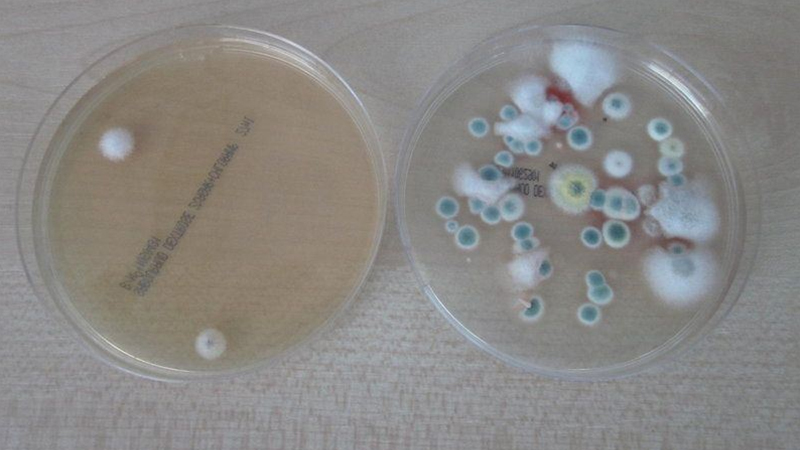
...
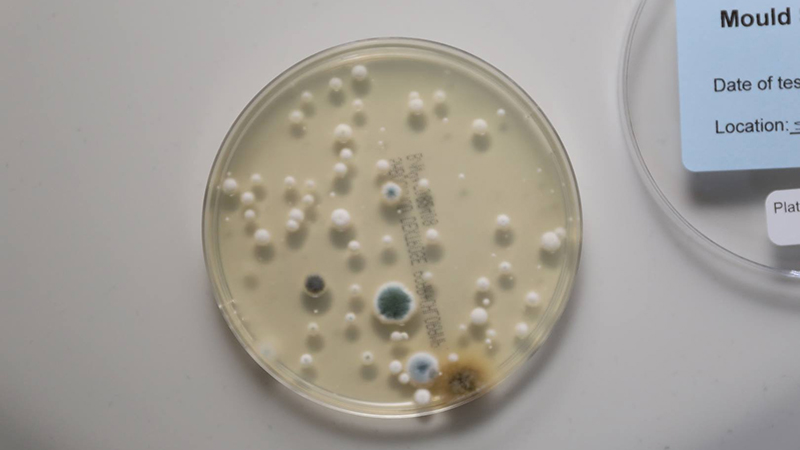
...

Address
No. 1 Goss House
The Street
The Street
Braintree
Essex
CM77 5AE
About Mouldcheck Limited
MouldCheck Limited is part of the Envirocheck (UK) Limited Group. Envirocheck has been providing high quality air and water monitoring and consultancy services to the commercial market since Dec 1999.
Envirocheck look after buildings for very large organisations throughout the country including work for Government Buildings, MOD and local authorities. We now bring this expertise to the residential market.
Products
We set up Mouldcheck Limited (September 2011) due to the demand for testing particularly mould in the home. We found that the commercial laboratory testing was too expensive and that laboratories would not deal with the general public.
We therefore have developed and imported tests to provide good quality analysis for the home at sensible prices. We have helped many people providing evidence of problems that often result in ill health.
We continue to offer good products and try to educate landlords, property owners and even the medical profession regarding the problems associated with long term exposure to high levels of mould spores in the air.
Envirocheck look after buildings for very large organisations throughout the country including work for Government Buildings, MOD and local authorities. We now bring this expertise to the residential market.
Products
- Mould Testing Kits
- Toxic Black Mould Kits
- DIY Sampling
- Bacteria Testing
- Hygiene Testing - Mould or Bacteria
- Water Testing
- Home Visits
- Legionella Risk Assessments - Domestic Properties
- Spa, Hot Tub and Pool Water Testing
We set up Mouldcheck Limited (September 2011) due to the demand for testing particularly mould in the home. We found that the commercial laboratory testing was too expensive and that laboratories would not deal with the general public.
We therefore have developed and imported tests to provide good quality analysis for the home at sensible prices. We have helped many people providing evidence of problems that often result in ill health.
We continue to offer good products and try to educate landlords, property owners and even the medical profession regarding the problems associated with long term exposure to high levels of mould spores in the air.
 London
London UK
UK Ireland
Ireland Scotland
Scotland